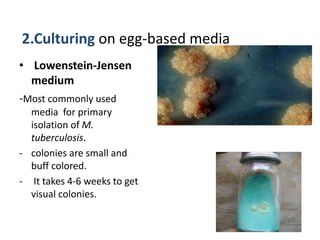
2.Culturing on egg-based media
• Lowenstein-Jensen
medium
-Most commonly used
media for primary
isolation of M.
tuberculosis.
- colonies are small and
buff colored.
- It takes 4-6 weeks to get
visual colonies.

This document discusses Mycobacterium tuberculosis and Mycobacterium leprae. M. tuberculosis causes tuberculosis and primarily affects the lungs, while M. leprae causes leprosy and affects superficial tissues like skin and nerves. Both are acid-fast bacilli with waxy cell walls. Laboratory diagnosis of M. tuberculosis involves examining sputum smears microscopically for acid-fast bacilli, culturing on egg-based media over 4-6 weeks, and nucleic acid amplification tests. Diagnosis of M. leprae involves examining skin and tissue samples microscopically after Ziehl-Neelsen staining or using PCR to detect its DNA.